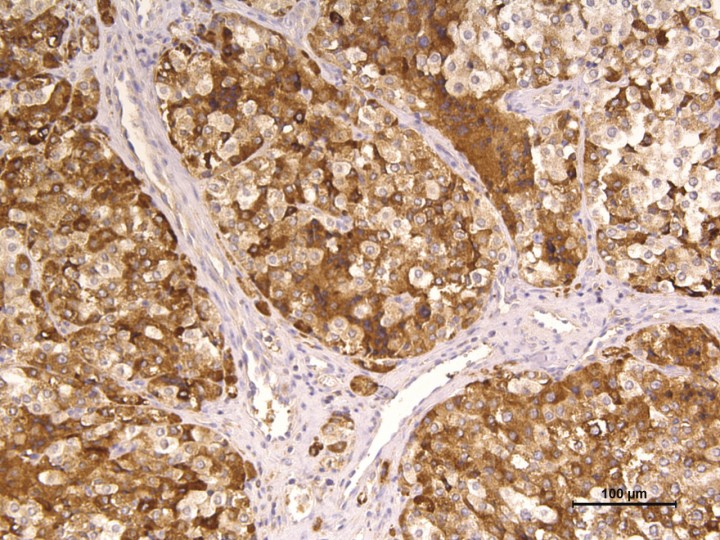
<p>Inmunohistoquímica frente a cromogranina. Nótese que todas las células neoplásicas presentan inmunopositividad citoplasmática intensa. 200x.</p>

Resumen
Un perro de raza Bulldog Francés, hembra no castrada de 9 años de edad, fue valorado por una historia de masa de crecimiento lento en la zona cervical y disnea inspiratoria. Después de la valoración clínica y el estudio citológico, por imagen e histológico se diagnosticó un quemodectoma carotídeo, el cual se trató con la combinación de tratamiento quirúrgico y quimioterápico. El presente artículo describe todo el protocolo diagnóstico y terapéutico de la patología, así como la evolución del paciente.
Abstract
A 9-years-old intact female French Bulldog was evaluated because of a slow-growing mass in the cervical area and inspiratory dyspnea. The clinical, diagnostic imaging and citology and histopathology features lead us to the diagnosis of a carotid chemodectoma, which was treated with the combination of surgical and chemoterapic treatment. This case presents the diagnostic and therapeutic protocol of the pathology, as well as the patient’s outcome.

La presencia de este logo en un artículo de la revista indica que se publicará un examen sobre el mismo en la plataforma AVEPA Elearning. Su resolución aporta 0,15 créditos dentro del sistema de acreditaciones de especialidades veterinarias de AVEPA.
Introducción
Los quimiorreceptores son agregados celulares de origen neuroectodérmico localizados a nivel de los grandes vasos. Actúan como barómetros regulando la función cardiorrespiratoria en respuesta a cambios en la presión de oxígeno, dióxido de carbono y pH de la sangre arterial.[ Capen C. Tumors of the chemorreceptor organs. En: Donald J Meuten, ed. Tumors in Domestic Animals. 4th edition; 2008:607-696. ]
Los quemodectomas (o paragangliomas no cromafinos) son los tumores originados en estos quimiorreceptores.[ MacPhail CM. Surgery of the cardiovascular system. Cardiac neoplasia. En: Fossum TW, ed. Small Animal Surgery. 4th edition. St Louis; 2013:896-898. ] Aunque pueden localizarse por todo el organismo, generalmente se encuentran en el cuerpo aórtico (en la pared de la aorta ascendente a nivel de la base cardíaca) o en el cuerpo carotídeo (a nivel de la bifurcación de la arteria carótida común en la región cervical).[ Capen C. Tumors of the chemorreceptor organs. En: Donald J Meuten, ed. Tumors in Domestic Animals. 4th edition; 2008:607-696. , MacPhail CM. Surgery of the cardiovascular system. Cardiac neoplasia. En: Fossum TW, ed. Small Animal Surgery. 4th edition. St Louis; 2013:896-898. ] Los quemodectomas son tumores poco frecuentes; sin embargo, los localizados a nivel aórtico tienen mayor incidencia que los carotídeos (relación 4:1).[ Yates W, Lester S, Mills J. Chemoreceptor tumors diagnosed at the Western College of Veterinary Medicine 1967-1979. Can Vet J 1980. 21(4):124-129. [PubMed] , Orton CE. Cardiac surgery. Cardiac neoplasia. En: Tobias KM, Johnston SA, ed. Veterinary surgery small animal. 1st edition. St Louis; 2012:1843-1844. ]
Se trata de tumores no funcionales; es decir, no secretan hormonas a circulación.[ Capen C. Tumors of the chemorreceptor organs. En: Donald J Meuten, ed. Tumors in Domestic Animals. 4th edition; 2008:607-696. , Treggiari E, Pedro B, Dukes-McEwan J, Gelzer A, Blackwood L. A descriptive review of cardiac tumours in dogs and cats. Vet Comp Oncol 2017. 15(2):273-288. [PubMed] ] Es por eso que generalmente se detectan de forma accidental.[ MacPhail CM. Surgery of the cardiovascular system. Cardiac neoplasia. En: Fossum TW, ed. Small Animal Surgery. 4th edition. St Louis; 2013:896-898. , Yates W, Lester S, Mills J. Chemoreceptor tumors diagnosed at the Western College of Veterinary Medicine 1967-1979. Can Vet J 1980. 21(4):124-129. [PubMed] , Orton CE. Cardiac surgery. Cardiac neoplasia. En: Tobias KM, Johnston SA, ed. Veterinary surgery small animal. 1st edition. St Louis; 2012:1843-1844. , Atasever A, Çam Y. Aortic body tumour in a dog. Turk J Vet Anim Sci 2003. 27:1241-1245. , Noszczyk-Nowak A, Nowak M, Paslawska U, Atamaniuk W, Nicpon J. Cases with manifestation of chemodectoma diagnosed in dogs in Department of Internal Diseases with Horses, Dogs and Cats Clinic, Veterinary Medicine Faculty, University of Environmental and Life Sciences, Wroclaw, Poland. Acta Vet Scand 2010. 52(35):1-7. [PubMed] ] Aun así, pueden causar signos clínicos debido al efecto masa, invasión o expansión local que producen.[ Capen C. Tumors of the chemorreceptor organs. En: Donald J Meuten, ed. Tumors in Domestic Animals. 4th edition; 2008:607-696. , Yates W, Lester S, Mills J. Chemoreceptor tumors diagnosed at the Western College of Veterinary Medicine 1967-1979. Can Vet J 1980. 21(4):124-129. [PubMed] , Obradovich JE, Withrow SJ, Powers BE, Walshaw R. Carotid body tumors in the dog. Eleven cases (1978-1988). J Vet Intern Med 1992. 6(2):96-101. [PubMed] , Fife W, Mattoon J, Drost WT, Groppe D, Wellman M. Imaging features of a presumed carotid body tumor in a dog. Vet Radiol Ultrasound 2003. 44(3):322-325. [PubMed] , Kromhout K, Gielen I, De Cock HE V, Van Dyck K, Van Bree H. Magnetic resonance and computed tomography imaging of a carotid body tumor in a dog. Acta Vet Scand 2012. 54(1):24. [PubMed] ]
Este tipo de tumores tienen un comportamiento generalmente benigno, con una tasa de metástasis presente en un tercio de los casos. Se consideran localmente invasivos, afectando a las estructuras cercanas.[ Yates W, Lester S, Mills J. Chemoreceptor tumors diagnosed at the Western College of Veterinary Medicine 1967-1979. Can Vet J 1980. 21(4):124-129. [PubMed] , Atasever A, Çam Y. Aortic body tumour in a dog. Turk J Vet Anim Sci 2003. 27:1241-1245. , Noszczyk-Nowak A, Nowak M, Paslawska U, Atamaniuk W, Nicpon J. Cases with manifestation of chemodectoma diagnosed in dogs in Department of Internal Diseases with Horses, Dogs and Cats Clinic, Veterinary Medicine Faculty, University of Environmental and Life Sciences, Wroclaw, Poland. Acta Vet Scand 2010. 52(35):1-7. [PubMed] , Obradovich JE, Withrow SJ, Powers BE, Walshaw R. Carotid body tumors in the dog. Eleven cases (1978-1988). J Vet Intern Med 1992. 6(2):96-101. [PubMed] , Fife W, Mattoon J, Drost WT, Groppe D, Wellman M. Imaging features of a presumed carotid body tumor in a dog. Vet Radiol Ultrasound 2003. 44(3):322-325. [PubMed] , Deim Z, Szalay F, Bauer A, Cserni G. Carotid body tumor in dog: a case report. Can Vet J 2007. 48(8):865-867. [PubMed] ] Los quemodectomas metastatizan, principalmente a pulmón, pero también a hígado, miocardio, riñones, linfonodos, glándulas adrenales, encéfalo y hueso.[ Capen C. Tumors of the chemorreceptor organs. En: Donald J Meuten, ed. Tumors in Domestic Animals. 4th edition; 2008:607-696. , Treggiari E, Pedro B, Dukes-McEwan J, Gelzer A, Blackwood L. A descriptive review of cardiac tumours in dogs and cats. Vet Comp Oncol 2017. 15(2):273-288. [PubMed] , Noszczyk-Nowak A, Nowak M, Paslawska U, Atamaniuk W, Nicpon J. Cases with manifestation of chemodectoma diagnosed in dogs in Department of Internal Diseases with Horses, Dogs and Cats Clinic, Veterinary Medicine Faculty, University of Environmental and Life Sciences, Wroclaw, Poland. Acta Vet Scand 2010. 52(35):1-7. [PubMed] , Obradovich JE, Withrow SJ, Powers BE, Walshaw R. Carotid body tumors in the dog. Eleven cases (1978-1988). J Vet Intern Med 1992. 6(2):96-101. [PubMed] , Kromhout K, Gielen I, De Cock HE V, Van Dyck K, Van Bree H. Magnetic resonance and computed tomography imaging of a carotid body tumor in a dog. Acta Vet Scand 2012. 54(1):24. [PubMed] , Naudé S, Miller D. Magnetic resonance imaging findings of a metastatic chemodectoma. J S Afr Vet Ass 2006. 77(3):155-159. [PubMed] ] Según localización, los tumores carotídeos tienden a tener un comportamiento más maligno que los aórticos, aunque es frecuente que estén presentes en ambas localizaciones.[ Capen C. Tumors of the chemorreceptor organs. En: Donald J Meuten, ed. Tumors in Domestic Animals. 4th edition; 2008:607-696. ]
En el presente artículo se describe un caso clínico de un Bulldog Francés de 9 años con una masa localizada a nivel cervical que, teniendo en cuenta los signos clínicos, localización y hallazgos patológicos, se diagnosticó como un quemodectoma carotídeo.
Caso clínico
Se presenta en consulta un Bulldog Francés, hembra no castrada de 9 años de edad, con historia de masa de crecimiento lento en la zona cervical y disnea inspiratoria.
El examen físico revela una masa de 2 x 2 cm aproximadamente en la zona ventral del cuello. No se detectan más alteraciones durante la exploración física inicial.
Ante la presencia de la masa cervical, se realiza un aspirado con aguja fina donde se observan células de tejido neuroendocrino, siendo el diagnóstico más probable por localización un tumor de origen tiroideo y, menos probable, otras neoplasias neuroendocrinas. Debido a los hallazgos de la exploración física y citológica se propone hacer un estadiaje del animal con hemograma, perfil bioquímico, T4 y TSH y ecografía abdominal y de la masa y, en función de los resultados, tomografía computerizada (TC), por una parte, de la región cervical para planear cirugía y, por otra, del tórax para descartar presencia de metástasis pulmonares.
No se detectan alteraciones en el hemograma, bioquímica y T4/TSH.
En la ecografía abdominal (MyLab Eight XP, equipado con sondas microconvex SC 3123 y lineal L415; Esaote, Génova, Italia) no se aprecian cambios significativos. En cuanto a la ecografía de la masa se observa una masa heterogénea, ovalada y bien delimitada a nivel cervical izquierdo, lateral a la glándula tiroides y a la arteria carótida común. Las dos tiroides se encuentran bien definidas, con ecogenicidad conservada y en su posición anatómica normal, con lo cual se concluye que se trata de una masa independiente de la glándula.
Para caracterizar mejor la lesión, descartar una metástasis no detectada con las pruebas realizadas y evaluar la viabilidad y extensión de una posible cirugía, se realiza una TC [Scanner 16 cortes; Brivo CT385, General Electric Healthcare, Fairfield, EE.UU. Parámetros: 120 kV; 70 mA; slice thickness: 1,25 mm; gap: 1,25 mm; pitch: 0,562:1, 1 segundo de rotación. Algoritmos de tejidos blandos y hueso, pre- y postadministración intravenosa de contraste yodado (2 ml/kg de Omniopaque 300, General Electric Healthcare, Fairfield, EE.UU.)].
En la TC se identifica la presencia de una masa cervical izquierda (3 cm de alto x 4 cm de ancho x 5,3 cm de largo), originada en el área de la carótida común izquierda y vena yugular interna a la altura de C3-C4 (Figs. 1 y 2A). Las tiroides resultan dentro de la normalidad. En el estudio poscontraste la masa realza de manera marcada y heterogénea. En su extensión dorsolateral, la masa se extiende hacia la porción dorsal, sobre todo izquierda, de laringofaringe y esófago craneal, causando efecto masa desplazando a la derecha la laringe y aparato hioideo, y ventrolateralmente a la derecha el esófago craneal (Figs. 2B y C). También desplaza dorsolateralmente a la izquierda la musculatura cervical hipoaxial, y la porción más rostral en el lado izquierdo se extiende dorsalmente hacia la base del cráneo, pero no se detecta infiltración intracraneal ni signos de lisis ósea en la base del cráneo (Fig. 3). Aunque la masa parezca bastante bien definida no se puede descartar una afectación de la laringe/laringofaringe y de la musculatura cervical. Se visualiza también una congestión venosa y arterial regional (arteria carótida común y vena yugular interna izquierdas) secundarias a la masa, y aunque no se detectan signos de trombosis u oclusión, no se puede descartar una invasión vascular de estos vasos que están envueltos por la masa.

Reconstrucción 3D sagital de la masa cervical izquierda (desde la base del cráneo hasta C3-C4, ventralmente) (ACC: arteria carótida común; VYE: vena yugular interna; T: tráquea).

Imágenes de TC poscontraste en ventana de tejido blando de la masa cervical izquierda. (A) Plano sagital. (B) Plano dorsal. (C) Plano transversal. Nótese el desplazamiento de la laringe (*). M: masa; A: atlas; B: bulla timpánica izquierda.

Sección sagital oblicua en ventana de tejido blando poscontraste. Nótese la extensión de la masa (M) hacia la base del cráneo (entre flechas).
La masa es compatible con un tumor de cuerpo carotídeo, con lo que se propone cirugía para la resección de la masa y realización de histopatología para poder emitir un diagnóstico definitivo.
Para ello, se posiciona al paciente en decúbito supino y un poco lateralizado hacia la izquierda para facilitar la visualización de la masa observada en la TC, que queda localizada en dicha posición. A través de la línea ventral media se incide piel, tejido subcutáneo y músculos esternohioideos. Se retraen lateralmente ambos esternohioideos y músculo esternotiroideo para visualizar el espacio visceral del cuello, ayudándonos de un separador Weittlaner y Farabeuf (Fig. 4A).

Imágenes intraquirúrgicas. (A) Retracción de los músculos esternohioideos (MEH) y esternotiroideos (MET) para permitir la observación de la masa (M) orientada craneal a la derecha y caudal a la izquierda. (B) Se aprecia la masa (M) tras reclinar el esófago (E). (C) Se puede observar la arteria carótida y vena yugular tras la extracción de la masa.
Se reclina tráquea y esófago pudiendo observar una masa bastante vascularizada en el área de la vaina carotídea y las estructuras contenidas en ella (arteria carótida común, tronco vagosimpático y vena yugular interna). Se disecciona cuidadosamente la vaina carotídea para separar la arteria carótida común junto al tronco vagosimpático de la masa, procediendo a la cauterización de varios vasos durante la extracción de la misma (Fig. 4B).
Tras extraer la totalidad de la masa (Fig. 4C), se procede al cierre del músculo esternohiodeo y esternotiroideo, la colocación de un drenaje Penrose y el cierre del tejido subcutáneo y piel mediante una sutura Monosyn 2/0.
Posteriormente a la cirugía se realiza una TC de control en la que se puede comprobar la resección completa de la masa.
La masa extraída es sometida a estudio histopatológico con el fin de poder emitir un diagnóstico definitivo. Macroscópicamente se trata de una masa de 3 x 4 cm (Fig. 5), polilobulada, de consistencia firme que, a la sección, muestra áreas blanquecinas y otras más oscuras. El estudio histológico revela una proliferación neoplásica multilobular parcialmente encapsulada, con áreas multifocales de invasión capsular, compuesta por paquetes de células separados por abundante estroma fibroso con presencia de numerosos vasos sanguíneos y nervios. Las células neoplásicas presentan un citoplasma pálido granular y un núcleo redondo central. El grado de atipia celular es moderado, observándose ocasionales células multinucleadas (Fig. 6). De forma puntual, se observan células neoplásicas en luces vasculares. Las células neoplásicas alcanzan todos los márgenes de resección quirúrgicos.

Totalidad de la masa extraída que evidencia sus dimensiones (3 x 4 cm).

Tinción de hematoxilina-eosina en la cual se aprecian paquetes compactos de células neoplásicas separados por trabéculas de tejido fibroconjuntivo. Las células neoplásicas tienen una forma de redonda a poliédrica y un citoplasma pálido granular. 100x.
Las células neoplásicas presentan una intensa positividad inmunohistoquímica frente a cromogranina (Fig. 7), por lo que se confirma el origen neuroendocrino del tumor.
Inmunohistoquímica frente a cromogranina. Nótese que todas las células neoplásicas presentan inmunopositividad citoplasmática intensa. 200x.
La localización de la masa, las características histopatológicas del tumor y el resultado positivo de la cromogranina son indicativas de un carcinoma del cuerpo carotídeo.
Ante este diagnóstico y debido a que se sospecha que no se ha podido extraer el tumor en su totalidad, se propone iniciar tratamiento con quimioterapia consistente en toceranib fosfato (Palladia®, Zoetis, Bélgica) a 2,5 mg/kg lunes, miércoles y viernes por vía oral, junto a omeprazol a dosis de 0,7 mg/kg cada 24 horas por vía oral.
Dos semanas después de la cirugía el animal se presenta de nuevo a la consulta para evaluar los posibles efectos adversos de la quimioterapia y el propietario refiere una historia progresiva de regurgitación. Se realizan radiografías torácicas en proyecciones ventrodorsal y lateral derecha, en las cuales se detecta la presencia de megaesófago (Fig. 8), el cual sería compatible con lesión de las vías nerviosas secundaria a la cirugía.

Radiografía lateral derecha de tórax. Se detecta distensión generalizada de moderada a marcada del esófago intratorácico.
Seis meses después de la cirugía el animal está estable, aunque sigue presentando regurgitación que se trata sólo con alimentación en posición elevada y metoclopramida (0,5 mg/kg/8h; Sanofi-Aventis S.A.; Barcelona) para evitar el reflujo. No presenta síntomas asociados a la administración de toceranib fosfato y tiene buena calidad de vida. Se decide realizar una TC de control en la que no se detectan nódulos o masas evidentes, ni otros cambios significativos en la porción cervical o el tórax (Fig. 9).

Control posoperatorio de la porción cervical en ventana de tejido blando poscontraste. (A) Plano transversal. (B) Plano sagital. No se detecta la masa previamente descrita. (B: bulla timpánica izquierda).
Discusión
Las razas braquicefálicas (sobre todo Bóxer, Boston Terrier y Bulldog) tienen mayor predisposición a sufrir quemodectomas.[ Capen C. Tumors of the chemorreceptor organs. En: Donald J Meuten, ed. Tumors in Domestic Animals. 4th edition; 2008:607-696. , MacPhail CM. Surgery of the cardiovascular system. Cardiac neoplasia. En: Fossum TW, ed. Small Animal Surgery. 4th edition. St Louis; 2013:896-898. , Yates W, Lester S, Mills J. Chemoreceptor tumors diagnosed at the Western College of Veterinary Medicine 1967-1979. Can Vet J 1980. 21(4):124-129. [PubMed] , Orton CE. Cardiac surgery. Cardiac neoplasia. En: Tobias KM, Johnston SA, ed. Veterinary surgery small animal. 1st edition. St Louis; 2012:1843-1844. , Noszczyk-Nowak A, Nowak M, Paslawska U, Atamaniuk W, Nicpon J. Cases with manifestation of chemodectoma diagnosed in dogs in Department of Internal Diseases with Horses, Dogs and Cats Clinic, Veterinary Medicine Faculty, University of Environmental and Life Sciences, Wroclaw, Poland. Acta Vet Scand 2010. 52(35):1-7. [PubMed] , Obradovich JE, Withrow SJ, Powers BE, Walshaw R. Carotid body tumors in the dog. Eleven cases (1978-1988). J Vet Intern Med 1992. 6(2):96-101. [PubMed] , Fife W, Mattoon J, Drost WT, Groppe D, Wellman M. Imaging features of a presumed carotid body tumor in a dog. Vet Radiol Ultrasound 2003. 44(3):322-325. [PubMed] , Tobias AH, Mcniel EA. Pericardial disorders and cardiac tumors. En: Tilley LP, Smith FW, Oyama MA, Sleeper MM, ed. Manual of Canine and Feline Cardiology. 4th edition. St Louis; 2008:200-214. , Headley SA, Bracarense AP, Nakagawa T, Moreno K, Pereira PM, Faria dos Reis AC. Aortic body tumors in dogs from Northern Paraná, Brazil. Ciência Rural 2009. 39(6):1908-1912. ] En nuestro caso se trataba de un animal de raza Bulldog Francés, lo que coincide con lo publicado en otros estudios. Parece ser que debido a la anatomía de la parte superior de su aparato respiratorio estas razas padecen un estado de hipoxia crónica, lo que resulta en una hiperplasia de los quimiorreceptores que puede predisponer a la aparición de una neoplasia.[ Capen C. Tumors of the chemorreceptor organs. En: Donald J Meuten, ed. Tumors in Domestic Animals. 4th edition; 2008:607-696. , MacPhail CM. Surgery of the cardiovascular system. Cardiac neoplasia. En: Fossum TW, ed. Small Animal Surgery. 4th edition. St Louis; 2013:896-898. , Orton CE. Cardiac surgery. Cardiac neoplasia. En: Tobias KM, Johnston SA, ed. Veterinary surgery small animal. 1st edition. St Louis; 2012:1843-1844. , Tobias AH, Mcniel EA. Pericardial disorders and cardiac tumors. En: Tilley LP, Smith FW, Oyama MA, Sleeper MM, ed. Manual of Canine and Feline Cardiology. 4th edition. St Louis; 2008:200-214. , Edwards C, Heath D, Harris P, Castillo Y, Krüger H, Arias-Stella J. The carotid body in animals at high altitude. J Pathol 1971. 104(4):231-238. [PubMed] , Hayes H, Fraumeni J. Chemodectomas in dogs: epidemiologic comparisons with man. J Natl Cancer Inst 1974. 52(5):1455-1458. [PubMed] ] Aun así, hay razas braquicefálicas que no tienen esta predisposición, por lo cual se cree que, además, también existe una predisposición familiar.[ Edwards C, Heath D, Harris P, Castillo Y, Krüger H, Arias-Stella J. The carotid body in animals at high altitude. J Pathol 1971. 104(4):231-238. [PubMed] , Hayes H, Fraumeni J. Chemodectomas in dogs: epidemiologic comparisons with man. J Natl Cancer Inst 1974. 52(5):1455-1458. [PubMed] ]
Los quemodectomas se presentan en animales de edad avanzada[ MacPhail CM. Surgery of the cardiovascular system. Cardiac neoplasia. En: Fossum TW, ed. Small Animal Surgery. 4th edition. St Louis; 2013:896-898. , Yates W, Lester S, Mills J. Chemoreceptor tumors diagnosed at the Western College of Veterinary Medicine 1967-1979. Can Vet J 1980. 21(4):124-129. [PubMed] , Noszczyk-Nowak A, Nowak M, Paslawska U, Atamaniuk W, Nicpon J. Cases with manifestation of chemodectoma diagnosed in dogs in Department of Internal Diseases with Horses, Dogs and Cats Clinic, Veterinary Medicine Faculty, University of Environmental and Life Sciences, Wroclaw, Poland. Acta Vet Scand 2010. 52(35):1-7. [PubMed] , Obradovich JE, Withrow SJ, Powers BE, Walshaw R. Carotid body tumors in the dog. Eleven cases (1978-1988). J Vet Intern Med 1992. 6(2):96-101. [PubMed] , Fife W, Mattoon J, Drost WT, Groppe D, Wellman M. Imaging features of a presumed carotid body tumor in a dog. Vet Radiol Ultrasound 2003. 44(3):322-325. [PubMed] , Deim Z, Szalay F, Bauer A, Cserni G. Carotid body tumor in dog: a case report. Can Vet J 2007. 48(8):865-867. [PubMed] , Tobias AH, Mcniel EA. Pericardial disorders and cardiac tumors. En: Tilley LP, Smith FW, Oyama MA, Sleeper MM, ed. Manual of Canine and Feline Cardiology. 4th edition. St Louis; 2008:200-214. , Headley SA, Bracarense AP, Nakagawa T, Moreno K, Pereira PM, Faria dos Reis AC. Aortic body tumors in dogs from Northern Paraná, Brazil. Ciência Rural 2009. 39(6):1908-1912. ] con mayor predisposición en machos, aunque existe cierta controversia según los estudios acerca de esta predisposición sexual.[ Capen C. Tumors of the chemorreceptor organs. En: Donald J Meuten, ed. Tumors in Domestic Animals. 4th edition; 2008:607-696. , Yates W, Lester S, Mills J. Chemoreceptor tumors diagnosed at the Western College of Veterinary Medicine 1967-1979. Can Vet J 1980. 21(4):124-129. [PubMed] , Noszczyk-Nowak A, Nowak M, Paslawska U, Atamaniuk W, Nicpon J. Cases with manifestation of chemodectoma diagnosed in dogs in Department of Internal Diseases with Horses, Dogs and Cats Clinic, Veterinary Medicine Faculty, University of Environmental and Life Sciences, Wroclaw, Poland. Acta Vet Scand 2010. 52(35):1-7. [PubMed] , Tobias AH, Mcniel EA. Pericardial disorders and cardiac tumors. En: Tilley LP, Smith FW, Oyama MA, Sleeper MM, ed. Manual of Canine and Feline Cardiology. 4th edition. St Louis; 2008:200-214. , Headley SA, Bracarense AP, Nakagawa T, Moreno K, Pereira PM, Faria dos Reis AC. Aortic body tumors in dogs from Northern Paraná, Brazil. Ciência Rural 2009. 39(6):1908-1912. ]
Aunque generalmente se detecten de forma accidental, pueden dar signos clínicos debido al efecto masa, invasión o expansión local que producen. En el caso concreto de los quemodectomas carotídeos, que es el que se describe en este caso, suelen causar disnea y disfagia por compresión de las vías respiratorias y esófago, y alteraciones circulatorias debido a la compresión de la arteria carótida común y sus ramas. Además, cuando se produce invasión de los tejidos locales, pueden provocar problemas neurológicos, tales como síndrome de Horner y parálisis laríngea, entre otros.[ Yates W, Lester S, Mills J. Chemoreceptor tumors diagnosed at the Western College of Veterinary Medicine 1967-1979. Can Vet J 1980. 21(4):124-129. [PubMed] , Obradovich JE, Withrow SJ, Powers BE, Walshaw R. Carotid body tumors in the dog. Eleven cases (1978-1988). J Vet Intern Med 1992. 6(2):96-101. [PubMed] , Fife W, Mattoon J, Drost WT, Groppe D, Wellman M. Imaging features of a presumed carotid body tumor in a dog. Vet Radiol Ultrasound 2003. 44(3):322-325. [PubMed] , Kromhout K, Gielen I, De Cock HE V, Van Dyck K, Van Bree H. Magnetic resonance and computed tomography imaging of a carotid body tumor in a dog. Acta Vet Scand 2012. 54(1):24. [PubMed] , Deim Z, Szalay F, Bauer A, Cserni G. Carotid body tumor in dog: a case report. Can Vet J 2007. 48(8):865-867. [PubMed] ] En nuestro caso, se observaba una disnea inspiratoria por desplazamiento de la tráquea debido a la masa, aunque se evidenció también la presencia de un síndrome braquiocefálico leve y movimientos laríngeos normales.
En cuanto al diagnóstico, la historia y el examen físico pueden ayudar (se puede detectar una masa a nivel cervical, lo que coincide con nuestro caso),[ Obradovich JE, Withrow SJ, Powers BE, Walshaw R. Carotid body tumors in the dog. Eleven cases (1978-1988). J Vet Intern Med 1992. 6(2):96-101. [PubMed] , Kromhout K, Gielen I, De Cock HE V, Van Dyck K, Van Bree H. Magnetic resonance and computed tomography imaging of a carotid body tumor in a dog. Acta Vet Scand 2012. 54(1):24. [PubMed] , Deim Z, Szalay F, Bauer A, Cserni G. Carotid body tumor in dog: a case report. Can Vet J 2007. 48(8):865-867. [PubMed] ] aunque no siempre se detectan alteraciones, y los valores hematológicos normalmente se encuentran dentro de los rangos de normalidad.[ Noszczyk-Nowak A, Nowak M, Paslawska U, Atamaniuk W, Nicpon J. Cases with manifestation of chemodectoma diagnosed in dogs in Department of Internal Diseases with Horses, Dogs and Cats Clinic, Veterinary Medicine Faculty, University of Environmental and Life Sciences, Wroclaw, Poland. Acta Vet Scand 2010. 52(35):1-7. [PubMed] , Obradovich JE, Withrow SJ, Powers BE, Walshaw R. Carotid body tumors in the dog. Eleven cases (1978-1988). J Vet Intern Med 1992. 6(2):96-101. [PubMed] ] La citología suele revelar un origen neuroendocrino, lo que en algunos casos puede ser difícil de diferenciar de neoplasias de origen tiroideo, como sucedió en nuestro caso. Si en la citología se observa material coloide o tiroglobulina en el interior de los agregados celulares, es más probable que se trate de una neoplasia tiroidea, pero estos hallazgos no se observaron en nuestro caso, lo que llevó al diagnóstico citológico de tumor de origen neuroendocrino.[ Obradovich JE, Withrow SJ, Powers BE, Walshaw R. Carotid body tumors in the dog. Eleven cases (1978-1988). J Vet Intern Med 1992. 6(2):96-101. [PubMed] , Fife W, Mattoon J, Drost WT, Groppe D, Wellman M. Imaging features of a presumed carotid body tumor in a dog. Vet Radiol Ultrasound 2003. 44(3):322-325. [PubMed] , Kromhout K, Gielen I, De Cock HE V, Van Dyck K, Van Bree H. Magnetic resonance and computed tomography imaging of a carotid body tumor in a dog. Acta Vet Scand 2012. 54(1):24. [PubMed] , Hardcastle M, Meyer J, McSporran K. Pathology in practice: Carotid and aortic body carcinomas (chemodectomas) in a dog. J Am Vet Med Assoc 2013. 242(2):175-177. [PubMed] ] Es por eso que es importante recurrir a otras técnicas diagnósticas tales como ecografía, resonancia magnética (RMI) y/o TC que permitan evaluar la correcta localización y extensión de la masa.[ Noszczyk-Nowak A, Nowak M, Paslawska U, Atamaniuk W, Nicpon J. Cases with manifestation of chemodectoma diagnosed in dogs in Department of Internal Diseases with Horses, Dogs and Cats Clinic, Veterinary Medicine Faculty, University of Environmental and Life Sciences, Wroclaw, Poland. Acta Vet Scand 2010. 52(35):1-7. [PubMed] , Fife W, Mattoon J, Drost WT, Groppe D, Wellman M. Imaging features of a presumed carotid body tumor in a dog. Vet Radiol Ultrasound 2003. 44(3):322-325. [PubMed] , Kromhout K, Gielen I, De Cock HE V, Van Dyck K, Van Bree H. Magnetic resonance and computed tomography imaging of a carotid body tumor in a dog. Acta Vet Scand 2012. 54(1):24. [PubMed] ]
En un estudio retrospectivo sobre la valoración de masas cervicales mediante técnicas de imagen, la diferenciación entre masas de origen linfoide (nódulos linfáticos retrofaríngeos mediales), tiroideas o tumores de cuerpos carotideos resultó muy difícil debido al efecto masa que causan y la dificultad de distinguir las diversas estructuras anatómicas. Los autores de ese estudio concluyen sobre la necesidad de localizar siempre las glándulas tiroides para reducir los diagnósticos diferenciales.[ Mai W, Seiler G, Lidl-Bylicki B, Zwingenberger A. CT and MRI features of carotid body paragangliomas in 16 dogs. Vet Radiol Ultrasound 2015. 56(4):374-383. [PubMed] ] En el presente estudio las glándulas tiroides fueron localizadas tanto por ecografía como por TC.
La histopatología[ Noszczyk-Nowak A, Nowak M, Paslawska U, Atamaniuk W, Nicpon J. Cases with manifestation of chemodectoma diagnosed in dogs in Department of Internal Diseases with Horses, Dogs and Cats Clinic, Veterinary Medicine Faculty, University of Environmental and Life Sciences, Wroclaw, Poland. Acta Vet Scand 2010. 52(35):1-7. [PubMed] , Obradovich JE, Withrow SJ, Powers BE, Walshaw R. Carotid body tumors in the dog. Eleven cases (1978-1988). J Vet Intern Med 1992. 6(2):96-101. [PubMed] , Kromhout K, Gielen I, De Cock HE V, Van Dyck K, Van Bree H. Magnetic resonance and computed tomography imaging of a carotid body tumor in a dog. Acta Vet Scand 2012. 54(1):24. [PubMed] , Deim Z, Szalay F, Bauer A, Cserni G. Carotid body tumor in dog: a case report. Can Vet J 2007. 48(8):865-867. [PubMed] ] e inmunohistopatología[ Capen C. Tumors of the chemorreceptor organs. En: Donald J Meuten, ed. Tumors in Domestic Animals. 4th edition; 2008:607-696. , Noszczyk-Nowak A, Nowak M, Paslawska U, Atamaniuk W, Nicpon J. Cases with manifestation of chemodectoma diagnosed in dogs in Department of Internal Diseases with Horses, Dogs and Cats Clinic, Veterinary Medicine Faculty, University of Environmental and Life Sciences, Wroclaw, Poland. Acta Vet Scand 2010. 52(35):1-7. [PubMed] , Deim Z, Szalay F, Bauer A, Cserni G. Carotid body tumor in dog: a case report. Can Vet J 2007. 48(8):865-867. [PubMed] ] permiten realizar el diagnóstico definitivo de estos tumores. En nuestro caso el estudio histopatológico confirmó que se trataba de un quemodectoma, pero no permitió revelar si se trataba de una masa expansiva o infiltrativa, ya que, al tratarse de una nodulectomía, los márgenes del tumor se correspondían con los márgenes de resección quirúrgicos. Sin embargo, dado que se observó invasión capsular de forma puntual así como invasión vascular, lo más probable es que se tratase de un crecimiento infiltrativo. La presencia de émbolos neoplásicos en vasos no es un factor predictivo de la presencia de metástasis en otros órganos.[ Capen C. Tumors of the chemorreceptor organs. En: Donald J Meuten, ed. Tumors in Domestic Animals. 4th edition; 2008:607-696. ]
En cuanto al tratamiento, una vez descartada la presencia de metástasis, la resección quirúrgica es siempre el tratamiento de elección en este tipo de tumores, pero la alta vascularización y asociación con los grandes vasos y nervios la dificulta.[ Obradovich JE, Withrow SJ, Powers BE, Walshaw R. Carotid body tumors in the dog. Eleven cases (1978-1988). J Vet Intern Med 1992. 6(2):96-101. [PubMed] ] Es por eso que las complicaciones posquirúrgicas son frecuentes (posibilidad de desarrollo de síndrome de Horner, parálisis laríngea u otras). En nuestro caso la complicación que se evidenció fue la presencia de megaesófago. Estas alteraciones son atribuibles a la invasión del tumor o a la resección quirúrgica accidental de vasos y nervios locales.[ Obradovich JE, Withrow SJ, Powers BE, Walshaw R. Carotid body tumors in the dog. Eleven cases (1978-1988). J Vet Intern Med 1992. 6(2):96-101. [PubMed] ] En nuestro caso, el megaesófago pudo tener su origen en un reflujo gástrico al tratarse de un animal braquiocefálico o deberse a la manipulación quirúrgica. Se fue resolviendo progresivamente con el paso del tiempo y no se observó en la TC de control de los 6 meses.
Se considera que la supervivencia en los animales tratados quirúrgicamente es mayor a los 12 meses.[ Obradovich JE, Withrow SJ, Powers BE, Walshaw R. Carotid body tumors in the dog. Eleven cases (1978-1988). J Vet Intern Med 1992. 6(2):96-101. [PubMed] ] Sin embargo, en esta misma referencia, 4/11 casos (36%) murieron en las dos semanas posteriores a la cirugía y un 50% de los que superaron las dos primeras semanas presentaron déficits neurológicos. Hay que tener en cuenta que es un artículo publicado hace 25 años y, obviamente, tanto las técnicas de imagen como quirúrgicas son actualmente superiores.[ Obradovich JE, Withrow SJ, Powers BE, Walshaw R. Carotid body tumors in the dog. Eleven cases (1978-1988). J Vet Intern Med 1992. 6(2):96-101. [PubMed] ]
Se ha descrito también el uso de quimioterapia y radioterapia como terapia coadyuvante.[ Hardcastle M, Meyer J, McSporran K. Pathology in practice: Carotid and aortic body carcinomas (chemodectomas) in a dog. J Am Vet Med Assoc 2013. 242(2):175-177. [PubMed] ] En nuestro caso, debido a la evidencia en medicina humana sobre el uso de sunitinib como tratamiento antiangiogénico en paragangliomas/feocromocitomas, se decidió usar un inhibidor tirosina quinasa.[ Joshua AM, Ezzat S, Asa SL, Evans A, Broom R, Freeman M et al. Rationale and evidence for sunitinib in the treatment of malignant paraganglioma/pheochromocytoma. J Clin Endocrinol Metab 2009. 94:5-9. [PubMed] ] Por ello, se decidió plantear el uso de toceranib fosfato (Palladia). Éste es un inhibidor multiquinasa que actúa sobre varios receptores tirosina quinasa, previniendo así la fosforilación del receptor y la consecuente transducción de la señal. La quimioterapia administrando toceranib (2,5-3,25 mg/kg) tiene actividad antiangiogénica, lo que frena el desarrollo de nuevos vasos sanguíneos alrededor del tumor y detiene así su crecimiento. Se puede administrar de forma única o como parte de un protocolo metronómico combinado con dosis bajas de quimioterápicos (generalmente ciclofosfamida o clorambucilo) y antiinflamatorios no esteroideos. Su uso en veterinaria ha mostrado eficacia en el tratamiento de carcinomas de sacos paraanales , carcinomas de glándula tiroides y en tumores de la cavidad nasal, principalmente.[ London C, Mathie T, Stingle N, et al. Preliminary evidence for biologic activity of toceranib phosphate (Palladia®) in solid tumours. Vet Comp Oncol 2012. 10(3):194-205. [PubMed] ]
En cuanto al uso de esta molécula en el tratamiento de quemodectomas, existe poca bibliografía al respecto y sólo hay artículos de casos puntuales que sugieren una prolongación de la supervivencia.[ Shin HR, Kim JS, Kim SM, Song KH, Seo KW. Metronomic chemoterapy with toceranib phosphate for treatment of a chemodectoma in a dog. J Vet Clin 2017. 34(1):43-46. ]
Se concluye, por lo tanto, que aunque sean neoplasias poco frecuentes, se deben incluir en el diagnóstico diferencial de masas cervicales y que deben combinarse diversas técnicas diagnósticas, tales como técnicas de imagen e histopatológicas, para llegar a su diagnóstico definitivo. En cuanto al tratamiento, el ideal se basa en la resección quirúrgica de la masa cuando se trata de tumores localizados y sin evidencia de metástasis en el estadiaje clínico. La quimioterapia más eficaz en estos casos está por determinar, aunque los inhibidores tirosin quinasa pueden jugar un papel relevante en algunos casos como sucede en medicina humana.
Agradecimientos
Los autores quieren agradecer a la Clínica Veterinaria Creu Blanca por la referencia del paciente y su colaboración, y al Dr. Carlos López Plana (Facultad de Veterinaria, Universitat Autònoma de Barcelona, Departamento de Sanidad Animal) por la identificación precisa de la región anatómica a intervenir.
Fuente de financiación: este trabajo no se realizó con fondos comerciales, públicos o del sector privado.
Conflicto de intereses: los autores declaran que no existe conflicto de intereses.
Bibliografía
- [1] Capen C. Tumors of the chemorreceptor organs. En: Donald J Meuten, ed. Tumors in Domestic Animals. 4th edition; 2008:607-696.
- [2] MacPhail CM. Surgery of the cardiovascular system. Cardiac neoplasia. En: Fossum TW, ed. Small Animal Surgery. 4th edition. St Louis; 2013:896-898.
- [3] Yates W, Lester S, Mills J. Chemoreceptor tumors diagnosed at the Western College of Veterinary Medicine 1967-1979. Can Vet J 1980. 21(4):124-129. [PubMed]
- [4] Orton CE. Cardiac surgery. Cardiac neoplasia. En: Tobias KM, Johnston SA, ed. Veterinary surgery small animal. 1st edition. St Louis; 2012:1843-1844.
- [5] Treggiari E, Pedro B, Dukes-McEwan J, Gelzer A, Blackwood L. A descriptive review of cardiac tumours in dogs and cats. Vet Comp Oncol 2017. 15(2):273-288. [PubMed]
- [6] Atasever A, Çam Y. Aortic body tumour in a dog. Turk J Vet Anim Sci 2003. 27:1241-1245.
- [7] Noszczyk-Nowak A, Nowak M, Paslawska U, Atamaniuk W, Nicpon J. Cases with manifestation of chemodectoma diagnosed in dogs in Department of Internal Diseases with Horses, Dogs and Cats Clinic, Veterinary Medicine Faculty, University of Environmental and Life Sciences, Wroclaw, Poland. Acta Vet Scand 2010. 52(35):1-7. [PubMed]
- [8] Obradovich JE, Withrow SJ, Powers BE, Walshaw R. Carotid body tumors in the dog. Eleven cases (1978-1988). J Vet Intern Med 1992. 6(2):96-101. [PubMed]
- [9] Fife W, Mattoon J, Drost WT, Groppe D, Wellman M. Imaging features of a presumed carotid body tumor in a dog. Vet Radiol Ultrasound 2003. 44(3):322-325. [PubMed]
- [10] Kromhout K, Gielen I, De Cock HE V, Van Dyck K, Van Bree H. Magnetic resonance and computed tomography imaging of a carotid body tumor in a dog. Acta Vet Scand 2012. 54(1):24. [PubMed]
- [11] Deim Z, Szalay F, Bauer A, Cserni G. Carotid body tumor in dog: a case report. Can Vet J 2007. 48(8):865-867. [PubMed]
- [12] Naudé S, Miller D. Magnetic resonance imaging findings of a metastatic chemodectoma. J S Afr Vet Ass 2006. 77(3):155-159. [PubMed]
- [13] Tobias AH, Mcniel EA. Pericardial disorders and cardiac tumors. En: Tilley LP, Smith FW, Oyama MA, Sleeper MM, ed. Manual of Canine and Feline Cardiology. 4th edition. St Louis; 2008:200-214.
- [14] Headley SA, Bracarense AP, Nakagawa T, Moreno K, Pereira PM, Faria dos Reis AC. Aortic body tumors in dogs from Northern Paraná, Brazil. Ciência Rural 2009. 39(6):1908-1912.
- [15] Edwards C, Heath D, Harris P, Castillo Y, Krüger H, Arias-Stella J. The carotid body in animals at high altitude. J Pathol 1971. 104(4):231-238. [PubMed]
- [16] Hayes H, Fraumeni J. Chemodectomas in dogs: epidemiologic comparisons with man. J Natl Cancer Inst 1974. 52(5):1455-1458. [PubMed]
- [17] Hardcastle M, Meyer J, McSporran K. Pathology in practice: Carotid and aortic body carcinomas (chemodectomas) in a dog. J Am Vet Med Assoc 2013. 242(2):175-177. [PubMed]
- [18] Mai W, Seiler G, Lidl-Bylicki B, Zwingenberger A. CT and MRI features of carotid body paragangliomas in 16 dogs. Vet Radiol Ultrasound 2015. 56(4):374-383. [PubMed]
- [19] Joshua AM, Ezzat S, Asa SL, Evans A, Broom R, Freeman M et al. Rationale and evidence for sunitinib in the treatment of malignant paraganglioma/pheochromocytoma. J Clin Endocrinol Metab 2009. 94:5-9. [PubMed]
- [20] London C, Mathie T, Stingle N, et al. Preliminary evidence for biologic activity of toceranib phosphate (Palladia®) in solid tumours. Vet Comp Oncol 2012. 10(3):194-205. [PubMed]
- [21] Shin HR, Kim JS, Kim SM, Song KH, Seo KW. Metronomic chemoterapy with toceranib phosphate for treatment of a chemodectoma in a dog. J Vet Clin 2017. 34(1):43-46.
Artículos recomendados
Estas recomendaciones se ofrecen de forma automática.
-
Fallo hepático en un perro tras intoxicación por ingestión de semillas de Cycas revoluta
C. García, A. Segarra, N. Bedía, et al.Clin Vet Peq Anim Vol. 45 - Nº 3 · SEP 2025 · Artículo original referido a un solo caso clínico -
Pseudoaneurisma venoso de presunto origen yatrogénico causado al realizar una biopsia ósea
F. Osorio, L. Feo, J. PuigClin Vet Peq Anim Vol. 45 - Nº 1 · MAR 2025 · Artículo original referido a un solo caso clínico -
Concordancia entre IDEXX SediVue Dx y el cultivo de orina en perros y gatos
L. Di Filippo, I. Frías, R. SantiagoClin Vet Peq Anim Vol. 44 - Nº 1 · MAR 2024 · Artículo original referido a múltiples casos clínicos


